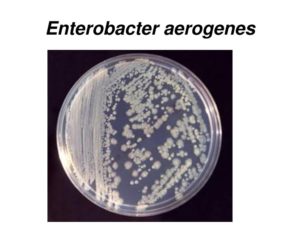
Бактерия enterobacter aerogenes
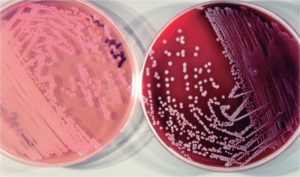
Бактерия enterobacter aerogenes

Энтеробактерии
Назад к списку
30.05.2012
(3 4,33 из 5)
Загрузка…
-
- Характеристика
- Заболевания
- Симптомы
- Лечение
Энтеробактерии (лат.
enterobacteriaceae) — семейство грамотрицательных (как и другие протеобактерии) палочкообразные (бациллы), споронеобразующие бактерии, длиной 1-5 мкм, со жгутиками для передвижения.
Эти бактерии — факультативные анаэробы, расщепляют углеводы с образованием муравьиной кислоты и других конечных продуктов формиатного брожения. Некоторые из них могут разлагать лактозу.
Множество представителей семейства являются частью микрофлоры кишечника человека и животных. Они представляют большое число нормальной микрофлоры человеческого организма и значительное количество патогенных микробов: сальмонелла, кишечная палочка, чумная палочка и др.
Энтеробактерии определяют в различных отделах желудочно-кишечного тракта здорового человека: в тощей кишке – от 0 до 103 КОЕ/мл, в подвздошной — от 102 до 106 КОЕ/мл. В норме в составе факультативной микрофлоры кишечника они не должны превышать количество 104 КОЕ/г.
Другая часть этих бактерий обнаруживается в воде и почве или паразитирует на различных растениях и животных. Хорошо изучена кишечная палочка — модельный организм, используемый в молекулярной биологии и генетике, в связи с изученностью её генетики и биохимии.
Энтеробактерии в воде и почве месяцами остаются жизнеспособными, но за несколько минут гибнут от дезинфектантов и при очень высоких температурах через 1 час.
Эти бактерии вырабатывают сахаролитические, протеолитические и др. ферменты, определение которых имеет таксонометрическое значение. Образуют индол, а глюкозу, лактозу, маннит ферментируют до кислоты и газа.
Факторами патогенности являются:
- эндотоксин, который освобождается после разрушения микробных клеток и адгезины,
- цитотоксин,
- экзотоксин.
Бактерии могут проникать в макрофаги и размножаться в них. Патологический процесс усугубляется на фоне снижения активности фагоцитоза, падения барьерной функции тканей.
Снижение в кишечнике полезной нормофлоры и нарушение колонизационной и защитной функции может приводить к проникновению в лимфу и кровь. Коли-бактериозы возникают при снижении количества полезной микрофлоры кишечника и иммунитета.
После перенесённого заболевания невосприимчивость не формируется.
Какие заболевания вызывают энтеробактерии?
энтреробактерии e.coli
Группа энтеробактерий включающая: сальмонеллы, шигеллы, эшерихии, клебсиеллы, собственно энтеробактер, серрации, протей, морганеллы, провиденции и иерсинии в норме обитают в желудочно-кишечном тракте человека, но при снижении защитных свойств слизистой кишечника, могут вызывать инфекции желудочно-кишечного тракта или других органов.
Энтеробактерии — представители родов citrobacier, ewardsiella, enterobacter, escherichia, hafnia, klebsiella, proteus, providencia, salmonella, serratia, yersinia вызывают инфекции мочеполовой системы (в том числе циститы, пиелонефриты, цервициты и т.п.). До 80% бактерий, обнаруживаемых в моче — энтеробактерии.
Энтеробактерии становятся причиной различных заболеваний человека.
Условно – патогенные бактерии вызывают гнойно-воспалительные процессы различной локализации: как эндогенные процессы – развиваются инфекции мочевыводящих путей (уретрит, цистит, пиелонефрит), половой системы (вагинит, трихомиоз, цервицит), дыхательных путей (пневмония), желудочно-кишечного тракта (холециститы, сальмонеллез, дизентерия, чума) и другие, так называемые коли-бактериозы, а как экзогенные – нагноение ран. Разные формы ОКЗ – острых кишечных заболеваний обусловлены патогенным действием различных энтеробактерий и чем агрессивнее токсины бактерий, тем тяжелее состояние, особенно у маленьких детей.
Escherichia coli – кишечная палочка в норме определяется в желудочно-кишечном тракте и синтезирует секреторные иммуноглобулины и колицины.
Они тормозят рост некоторых патогенных энтеробактерий и препятствуют проникновению их в слизистую оболочку стенки кишечника. E. сoli участвует синтезе витамина К (свертываемость).
Некоторые патогенные штаммы кишечной палочки могут поражать слизистую кишечника, что проявляется кровавым водянистым поносом или диареей путешественников.

У детей диарея, вызываемая патогенной энтерогеморрагической кишечной палочкой, может осложняться гемолитико-уремическим синдромом и почечной недостаточностью. Эта бактерия может поражать кровь, желчный пузырь, легкие, мочевыводящие пути и кожу. У новорожденных детей, особенно недоношенных, кишечная палочка может стать патогенным возбудителем бактериемии и менингита.
Инфекции, обусловленные клебсиеллами (Klebsiella), энтеробактериями (Enterobacteriaceae) и серрациями (Serratia), обычно встречаются в больницах, чаще при снижении способности бороться против инфекций. Эти бактерии также часто поражают мочевыводящие, половые органы. Пневмония, вызванная клебсиеллами, наиболее распространена у больных сахарным диабетом и у злоупотребляющих алкоголем и имеет часто тяжелое течение.
Симптоматика инфекций, вызываемых энтеробактериями
Симптомы инфекционного заболевания могут быть различны, в зависимости от места развития воспалительного процесса, однако все больные жалуются на общую слабость, повышение температуры, проявления интоксикации и боли в месте заболевшего органа. Для определения патогенных энтеробактерий обязательно нужно сдать анализы – кровь, мочу, мокроту, мазки или кал, в зависимости от локализации воспалительного процесса, пройти до обследование, для выявления функциональных нарушений.
Важно соблюдать правила личной гигиены, следить за качеством, чистотой овощей-фруктов, питаться, учитывая индивидуальные особенности, избегать контакта с инфекционными больными и поддерживать свой иммунитет в норме.
Как быстро восстановиться после инфекции?
Восстановление и сохранение достаточного количества полезной нормофлоры кишечника – лакто- и бифидобактерий, способствует защите слизистой кишечника от проникновения патогенных бактерий и их токсинов в кровь и лимфу, выведению токсинов, созданию среды, в которой патогенные микроорганизмы не могут продолжать свою жизнедеятельность и выводятся из организма человека. Важно, что продукты жизнедеятельности полезных бактерий помогают иммунитету сохранять активность в борьбе с вредными бактериями.
Синбиотический биокомплекс Нормофлорины – содержащий живые активные лакто- и бифидобактерии и их метаболиты с противовоспалительным, антисептическим, иммуногенным и питательным действием на слизистые за многие годы зарекомендовал себя, как активный помощник и борец против патогенных бактерий для малышей и взрослых, беременных и больных с различными заболеваниями. Достаточно быстро при употреблении Нормофлоринов снимается интоксикация и восстанавливается функция кишечника, общее самочувствие.
Рекомендуется: как можно раньше начать принимать Нормофлорины в возрастных дозировках – Л – за 10-15 мин до еды утром (+ обед при запорах), Д – обед или вечер за 20 мин до еды, Б – на ночь или в микроклизме.
Длительность приема 3-4 недели, до полного восстановления функции кишечника и улучшения общего самочувствия.
Желательно 10-14 дней натощак принимать сорбенты – для выведения токсинов – зостерин или пекто, они уменьшают гнилостные, бродильные процессы, повышенное газообразование, улучшают работу кишечника.
Важно закрепить эффект восстановления микрофлоры, улучшить работу поджелудочной железы, печени, кишечника, иммунитет – для этого хорошо далее в течение месяца использовать функциональное питание – Гармония жизни. В её составе также содержатся живые полезные лакто- и бифидобактерии, их метаболиты и пектин. Вкусно, полезно и эффективно!
Назад к списку
Опасность бактерий рода энтеробактер для человека — Мир Бактерий
Энтеробактерии — большая группа микроорганизмов, обитающих в различных отделах ЖКТ и оказывающих позитивное или патогенное воздействие на организм человека. Все энтеробактерии подразделяются на три группы: патогенные, условно-патогенные и сапрофитные.
- Большинство энтеробактерий являются представителями микробного биоценоза кишечника. Это клебсиелла, энтеробактер, серрация, протей, цитробактер, провиденция и иерсиния. Они выполняют в макроорганизме жизненно важные функции, но под воздействием негативных факторов становятся опасными и вызывают различные заболевания.
- К абсолютным патогенам относятся шигеллы, сальмонеллы и некоторые виды эшерихий. Эти микробы, попав в организм человека извне, вызывают острые кишечные инфекции и прочие патологии, угрожающие жизни больного.
- Сапрофитные энтеробактерии не опасны в эпидемиологическом отношении и не имеют значения для практической медицины.
возбудители кишечных инфекций
В семейство Enterobacteriaceae входит множество родов и видов, способных вызвать развитие серьезных заболеваний у человека. Одним из основных представителей данного семейства является энтеробактер.
Он считается нормальным обитателем кишечника человека, обеспечивающим его адекватное функционирование. Проникая в другие органы, этот микроб становится причиной серьезных недугов. Чаще всего поражаются почки, мочевыводящие пути, органы репродуктивной и дыхательной систем.
Enterobacter spp – одна из ведущих причин смерти новорожденных детей.
Этиология
Энтеробактерии — аспорогенные палочковидные бактерии, способные развиваться и размножаться как в присутствии кислорода, так и без него.
Микробы имеют жгутики, обеспечивающие их подвижность, а некоторые образуют капсулу. По Граму они окрашиваются в красный цвет.
Большинство бактерий ферментируют углеводы до кислоты и газа, являются оксидазоотрицательными и каталазоположительными, а также способными к денитрификации.
Энтеробактерии получают энергию из химических соединений. В качестве источника углерода они используют органические вещества. Бактерии растут на универсальных питательных средах, обязательным компонентом которых является лактоза.
Они формируют характерные колонии: на Эндо – красные блестящие слизистые или мелкие бледно-розовые без отпечатка на среде, на Плоскирева – кирпично-красные, цвета среды или желтоватые колонии.
При выращивании в бульоне Хоттингера бактерия вызывает равномерное помутнение с выпадением осадка. Температурный оптимум для них — 35-36 градусов.
Факторы патогенности бактерий:
- Ферменты,
- Эндотоксин,
- Белки-адгезины,
- Энтеротоксин,Ммикроворсинки.
Энтеробактерии отличаются высокой выживаемостью. Они устойчивы к большинству антисептиков, дезинфектантов и противомикробных средств.
Эпидемиологическое значение
Потенциально-патогенные энтеробактерии — постоянные «жители» человеческого организма, обитающие на эпителии кишечника в строго определенном количестве, которое не должно превышать 104 КОЕ/г. Под воздействием эндогенных или экзогенных факторов микробы начинают активно размножаться, утрачивают свои полезные качества и приобретают болезнетворные свойства.
В организме формируется кишечный дисбиоз. При этом оппортунистические микробы начинают покидать пределы кишечника и, попадая в другие биоценозы, вызывать развитие различных недугов. Нередко инфекционная патология затрагивает органы мочевыделения, гепатобилиарной зоны, нервной системы. Со временем появляется доминирующий вид бактерий, который угнетает рост других.
Он и становится непосредственной причиной патологии.
Патогенные бактерии — обитатели объектов внешней среды: водоемов, почвы, флоры и фауны. Широкое распространение микробов в природе не позволяет человеку полностью обезопасить себя.
Enterobacter cloacae при нормальных условиях не приносят вреда человеку. Они мирно сосуществуют с макроорганизмом без ущерба для здоровья. Бактерии обычно поражают больных в лечебных учреждениях, получающих длительную антибиотикотерапию. Они не опасны для здорового организма.
Вместе с клебсиеллой, цитробактером, протеем и стафилококком энтеробактеры заселяют пищеварительный тракт. Большинство микробов из рода Enterobacter непатогенны для человека. Бактерии приобретают болезнетворные свойства при резком снижении иммунной защиты.
Резервуаром инфекции является больной человек или животное, в организме которого персистирует микроб. Вместе с калом больных энтеробактер попадает в окружающую среду. При этом фекалии становятся источником заражения.
Входными воротами инфекции является ЖКТ.
Распространение энтеробактерий происходит фекально-оральным или контактно-бытовым механизмами, которые реализуются алиментарным, водным, контактным, артифициальным и даже половым путями.
Патогенез
Заболевания, обусловленные энтеробактериями, чаще всего развиваются у лиц с иммунодефицитом.
Группу риска по энтеробактериальной инфекции составляют:
- Новорожденные,
- Пожилые люди,
- Часто болеющие лица,
- Больные хроническими патологиями ЖКТ,
- Пациенты, длительно находящиеся на стационарном лечении.
Кишечные микробы вызывают не только заболевания органов пищеварения, но и близлежащих структур. Воспаление может развиться практически в любой части тела человека: от зева до ануса.
Патологии, которые вызывают энтеробактерии:
- Дисбактериоз, дизентерия, сальмонеллез, эшерихиоз.
- Воспаление мочевыводящих путей и органов.
- Пневмония.
- Менингит, абсцедирование мозговой ткани и прочие ликворные нарушения.
- Инфекция органов женской репродуктивной системы.
- Воспаление органов гепатобилиарной зоны.
- Гематогенные расстройства — бактериемия, сепсис.
Энтеробактерии являются возбудителями внутрибольничных инфекций. Микробы проникают в кровяное русло при проведении инвазивных манипуляций, катетеризации мочевого пузыря или внутривенного введения нестерильных лекарств. В обширных очагах довольно сложно снизить активность бактерий.
В результате взаимодействия возбудителя и соответствующих структур макроорганизма развивается инфекционный процесс, который состоит из адгезии, инвазии, колонизации, токсинообразования.
Энтеробактер обладает тропизмом к эпителиоцитам кишечника. Адгезия осуществляется за счет приближения микроба, а также взаимодействия его ворсинок с рецепторами эпителия. Бактерии проникают внутрь клетки и начинают активно размножаться. Процессы колонизации и токсинообразования определяют выраженность и разнообразие клинических проявлений инфекции.
Симптоматика
Энтеробактериозы обычно протекают без каких-либо особенностей в симптоматике. Клинические признаки заболеваний определяются локализацией очага поражения и видом возбудителя.
Общие проявления патологии:
- Боль в очаге поражения различной интенсивности, длительности, распространенности.
- Общее недомогание, слабость, вялость, разбитость, снижение работоспособности.
- Признаки воспаления на гемограмме – лейкоцитоз и подъем СОЭ.
- Лихорадка, озноб, миалгия, артралгия, бледность кожи, снижение аппетита, нарушение сознания.
- Диспепсия — тошнота, рвота, изжога, метеоризм.
- Нарушение стула — изменение консистенции, появление патологических примесей.
Enterobacter aerogenes является возбудителем менингита, который нередко осложняется абсцедированием вещества мозга. У больных возникает интоксикация, очаговые неврологические симптомы, менингеальные знаки. При поражении мочевыводящих путей у больных появляется дизурия, боль в конце акта мочеиспускания.
Воспаление желчного пузыря и протоков проявляется болью и спазмами в правом подреберье. Воспалительный процесс в легочной ткани развивается у каждого четвертого носителя. У больных на фоне выраженной интоксикации возникает кашель с гнойной мокротой.
При отсутствии соответствующей терапии формируются тяжелые осложнения – коллапс и шок.
Диагностика
Диагностика энтеробактериальной инфекции заключается в проведении лабораторных исследований. Специалисты выслушивают жалобы больных, собирают анамнез жизни и болезни, проводят общий осмотр.
Лабораторная диагностика:
- В гемограмме — лейкоцитоз, сдвиг формулы влево, подъем СОЭ.
- Бакпосев мочи проводится с целью выделения возбудителя патологии органов мочевыделения. Бактериурия — содержание в 1 мл мочи более 105 микробных тел энтеробактерий. Когда этот признак сочетается с выраженной и характерной симптоматикой, требуется незамедлительное лечение в стационаре.
- Исследование кала проводят с целью определения причины кишечной дисфункции. Для выявления патогенных бактерий у больных берут мазок из прямой кишки и делают посев на среды, содержащие специальные красители и углеводы. Для этого используют простые пластинчатые среды Эндо, Плоскирева, висмут-сульфитный агар, а также среды накопления — селенитовый бульон или магниевую среду. После суточной инкубации изучают характер роста и проводят дальнейшую идентификацию путем изучения биохимических свойств на средах цветного ряда. В окрашенных по Граму мазках обнаруживают красные короткие палочки, образующие цепочки или располагающиеся хаотично. Enterobacter cloacae на твердых питательных средах образует слизистые лактозонегативные колонии. Подтверждают предполагаемый диагноз с помощью реакции агглютинации на стекле. После обнаружения возбудителя патологии проводят тест на чувствительность к антибиотикам и фагам.
- Микробиологический анализ кала на условно-патогенные энтеробактерии проводится количественным методом. Для этого нативный кал пациента суспендируют в физрастворе и готовят ряд его десятикратных разведений. Затем производят высев из каждого разведения на селективные среды. Для энтеробактера используют чашечную среду Симмонса. После инкубации изучают рост культуры, подсчитывают количество характерных колоний и готовят препарат для микроскопии. Расчет производят по специальным формулам. В норме общее число энтеробактерий не должно превышать 104 КОЕ в 1 грамме фекалий. Увеличение этого количества является признаком кишечного дисбиоза.
- Постановку диагноза при пневмонии, вызванной энтеробактериями, облегчает микробиологическое исследование мокроты на микрофлору.
- При бактериемии выделяют возбудителя по гемокультуре или проводят анализ крови на стерильность.
- Энтеробактерии в мазке у женщин можно обнаружить во время микробиологического исследования отделяемого влагалища или цервикального канала на микрофлору. Если наблюдается сплошной рост на чашках или количество характерных колоний превышает 100, делают вывод об этиологической роли энтеробактерий.
- Вспомогательные методы – УЗИ желчного пузыря, поджелудочной железы, почек и эндоскопическое исследование желудка и кишечника.
Методы лечения
Лечение энтеробактериальной инфекции этиотропное, антибактериальное. Его назначают после определения локализации поражения. На начальных стадиях заболевания, когда этиология не выяснена, проводят эмпирическую терапию.
Врачи назначают лекарства на основе видимых симптомов, руководствуясь собственным опытом. При доброкачественном течении заболевания подобное лечение позволяет устранить все симптомы в течение 6-12 дней. Во всех остальных случаях показано лечение антибиотиками.
Больные из группы риска лечатся исключительно антибактериальными препаратами после полной идентификации патогенного организма.
Обычно применяют антибиотики широкого спектра из группы пенициллинов «Амоксиклав», «Аугментин», цефалоспоринов «Цефтриаксон», «Цефазолин», аминогликозидов «Кларитромицин», «Азитромицин», фторхинолонов «Ципрофлоксацин», «Офлоксацин».
У разных штаммов бактерий чувствительность к этим препаратам может существенно отличаться. Специалисты часто комбинируют антибактериальные средства и назначают препараты, усиливающие действие антибиотиков и стимулирующие иммунную систему организма.
Дополнительно назначают пре- и пробиотики – «Линекс», «Хилак форте», «Бифиформ», а также иммуномодуляторы «Исмиген», «Полиоксидоний».
Симптоматическая терапия проводится по принципам лечения острых кишечных инфекций. Больным назначают спазмолитики «Но-шпу», «Спазмалгон», обволакивающие средства «Смекту», противорвотные препараты «Мотилиум», «Церукал», энтеросорбенты «Полисорб», «Пипольфен», ферменты — «Креон-Д», «Мезим», «Панзинорм», лекарства от вздутия – «Эспумизан», «Редугаз», витаминные комплексы.
Чтобы лечение было максимально эффективным и дало результаты в кратчайшие сроки, необходимо соблюдать щадящую диету. Диетотерапия заключается в исключении из рациона алкоголя, жирных, жареных, острых, соленных, пряных блюд, кондитерских изделий, хлебобулочной продукции, овощей и фруктов, содержащих много клетчатки и усиливающих процессы газообразования в кишечнике.
Рекомендованы кисломолочные продукты, легкоусвояемые блюда и перетертые пюре, не раздражающие слизистую ЖКТ. Готовить следует на пару. Больным показано дробное питание небольшими порциями через каждые 2-3 часа. Строгий рацион — необходимое условия в период лечения и восстановления.
Соблюдение принципов правильного лечебного питания позволит организму реабилитироваться после болезни за 2-3 дня.
Своевременное и адекватное лечение делает прогноз заболевания благоприятным. Проблемы со стулом и общим самочувствием могут длительно сохраняться у пожилых людей, маленьких детей и лиц с ослабленным иммунитетом.
Профилактические мероприятия
Профилактические мероприятия, предупреждающие развитие заболеваний, вызванных энтеробактериями:
- Укрепление иммунитета,
- Соблюдение гигиенических норм и правил,
- Употребление в пищу качественных продуктов питания, чистых овощей и фруктов, термически обработанных мясных изделий,
- Исключение контактов с больными ОКИ,
- Проведение в домашних условиях влажной уборки с периодическим мытьем индивидуальных бытовых предметов,
- в чистоте жилища и прилегающей территории,
- Поддержание иммунитета на оптимальном уровне — закаливание, правильное питание, физическая активность, отсутствие стрессов, борьба с вредными привычками.
При появлении признаков кишечного расстройства и дискомфорта в животе показан профилактический прием пре- и пробиотиков, витаминов и минеральных веществ.
Опасность бактерий рода Энтеробактер для человека. Обнаружение энтерококка фекального в анализе моче
Бактерии рода Enterobacter относятся к семейству enterobacteriaceae и включают в себя 12 видов, относящихся преимущественно к условно патогенной флоре, населяющей кишечник человека. Наибольший интерес для медиков имеют энтеробактеры, которые при определенных условиях способны вызывать заболевания у людей.
- Enterobacter cloacae является представителем нормальной микрофлоры дистального отдела кишечника. Но после приема антибиотиков, при снижении иммунитета или развитии дисбактериоза, его усиленное размножение приводит к нарушению работы ЖКТ. Из-за непосредственной близости ануса к наружным половым органам у женщин может происходить инфицирование, приводящее к вагинитам, цервицитам и воспалениям других отделов мочеполовой системы. Развитие микроорганизмов в дыхательных путях приводит к тяжелой форме пневмонии, а вот проникновение их в кровяное русло вызывает септицемию.
- Enterobacter aerogenes чаще других микробов является причиной больничных инфекций. Особую опасность представляет инфицирование внутрисосудистых катетеров, шунтов и протезов, провоцирующее инфекционный эндокардит, тромбофлебит или общий сепсис.
- Enterobacter agglomerans, обозначенные в современной литературе термином Pantoea agglomerans, поражают преимущественно органы мочеполовой системы мужчин и женщин, а также респираторный тракт.
- Enterobacter sakazakii, отнесенный в последнее время к роду Cronobacter, представляет большую опасность для новорожденных детей, особенно, имеющих недостаточную массу тела, аномалии развития и врожденные заболевания иммунной системы. Доказано, что Энтеробактер саказаки вызывает инфекционное воспаление оболочек головного и спинного мозга, образование некротических очагов на стенках кишечника, явления сепсиса.
- Enterobacter gergoviae, переименованный в Pluralibacter gergoviae, вызывает кишечные расстройства, поражения органов выделения, дыхания и размножения.
Другие условно патогенные бактерии рода энтеробактер, к которым относятся Enterobacter asburiae, Enterobacter hormaechei, Enterobacter ludwigii и Enterobacter kobei поражают преимущественно ЖКТ и респираторные органы.
Обнаружить микроб можно в разных средах человеческого организма
Иногда в результатах анализов встречается термин «лактозонегативные энтеробактерии», что указывает на наличие микроорганизмов, препятствующих правильному перевариванию продуктов и вызывающих изжогу, метеоризм, диарею, срыгивание и другие диспептические явления. В составе нормальной микрофлоры их количество не должно превышать 5%.
Таксономическая принадлежность
Род: Enterobacter
Семейство: Enterobacteriaceae
Группа: V грамотрицательные факультативные анаэробы
Отдел: I грамотрицательные микроорганизмы
Царство: Prokaryote
Название рода было утверждено в 1963 году. Но проведенные в последующем исследования генома привели к существенным изменениям в систематике. В результате этого E.agglomerans выделили в отдельный род Pantoea, а E.sakazakii отнесли к роду Cronobacter.
Поэтому современная классификация включает 12 видов бактерий рода энтеробактер, из которых наибольшее эпидемиологическое значение имеют энтеробактер клоака и аэрогенес.
Строение, жизненный цикл и свойства микробов
По внешнему строению энтеробактеры напоминают прямые палочки. Их тело полностью покрыто жгутиками, обеспечивающими движение. Единственным неподвижным видом является E.asburiae.
Выращивание в лабораторных условиях позволяет выявить Enterobacter в анализах
https://youtube.com/watch?v=XdzR97BUqSo
Диаметр микроорганизмов колеблется от 0,6 до 1 мкм, а длина — от 1.2 до 3 мкм. При диагностическом исследовании в мазках обнаруживаются единичные или соединенные в короткие цепочки бактерии. Все представители кишечной группы рода энтеробактер быстро растут на стандартных и селективно-дифференциальных питательных средах.
Бактерии принадлежат к группе факультативных анаэробов, не образуют спор, но у некоторых штаммов имеются капсулы. Местом их обитания являются слизистые оболочки кишечного тракта, органов мочеполовой системы и дыхания. При этом микроорганизмы способны выживать в экскрементах, почве, водоемах, на растениях, кожных покровах животных и других объектах внешней среды.
Род энтеробактер становится заразен для людей в период снижения резистентности организма или после длительного курса антибиотикотерапии. В первую очередь ускоряется пролиферация Enterobacter cloacae в тонком кишечнике, что для данных бактерий не характерно, так как большинство их населяет толстый отдел.
Энтеробактеры опасны для новорожденных младенцев с ослабленным иммунитетом в период прохождения через родовые пути. Инфицирование человека может произойти при попадании большого количества микроорганизмов с недоброкачественными продуктами питания или при заглатывании воды в открытых водоемах.
Низкая чувствительность к антибиотикам у представителей энтеробактер приводит к тому, что они быстро замещают лакто- и бифидобактерии, количество которых резко снижается во время продолжительного применения человеком антибиотиков. Такой дисбактериоз приводит к возникновению заболеваний.
Лабораторная диагностика: что означают цифры
У взрослого человека в кишечнике содержание микроорганизмов рода энтеробактер, включающих в себя Enterobacter cloacae, aerogenes и другие виды, не должно превышать 104 колониеобразующих единиц на 1 г кала.
Бактерии энтеробактер в кале ребенка появляется с первых дней жизни, но его количество и соотношение с другими микроорганизмами будет постоянно изменяться, так как в первые 3-4 месяца идет интенсивное заселение кишечника. Искусственное введение в организм малыша бифидо и лактобактерий позволяет поддерживать баланс микрофлоры кишечника.
При выявлении у новорожденных детей пневмонии, возникает подозрение на инфицирование их во время прохождения родовых путей.
В этом случае у матери в мазке из цервикального канала обнаруживается Enterobacter aerogenes с концентрацией более 105КОЕ.
Чтобы предотвратить такой путь заражения беременным проводят бакпосев на обнаружение Enterobacter aerogenes, Cronobacter sakazakii и некоторых других микроорганизмов, выявляемых при обычном бакпосеве.
Инфицирование ребенка может произойти, если в грудном молоке матери высеян энтеробактер, концентрация которого превышает допустимые показатели. Однако диагноз подтверждается после возникновения характерных клинических признаков и обнаружении Enterobacter cloacae в кале у ребенка в количестве, превышающем 104КОЕ.
Анализ мочи проводится для выяснения причин возникновения урогенитальных инфекций и выявления скрытых воспалений почек и мочевого пузыря.
Если при отсутствии клинических симптомов у женщин концентрация энтеробактер в 1 мл мочи превышает 105КОЕ, то диагноз подтверждается, и назначается курс лечения.
Если же количество в моче Enterobacter cloacae ниже данного показателя, то это свидетельствует о загрязнении лабораторного материала во время его забора.
Если клиника заболевания имеет выраженный характер, то допустимый порог в 1 мл мочи составляет не более Enterobacter cloacae 10 в 4 степени.
Делая посев из зева, следует знать, какая норма энтеробактер аэрогенес должна быть у человека, так как ее превышение может спровоцировать тяжелую форму пневмонии. Если показатель превышает Enterobacter aerogenes 10 2КОЕ и сопровождается клиническими признаками, то следует начинать немедленное лечение.
Пациенты, у которых выявлено наличие энтеробактера клоаке в горле, но не имеющие симптомов поражения респираторного тракта, считаются носителями. У них значительно повышается риск возникновения пневмонии при попадании в условия стационара, так как на ее долю приходится 10% случаев от совокупности внутрибольничных инфекций.

Для определения рисков инфекции разработаны стандарты лабораторной диагностики
Норма энтеробактер клоаке в зеве составляет от 102 до 104КОЕ, но при этом их количество не должно значительно превышать концентрацию других форм нормальной микрофлоры.
В чем опасность для человека
Наибольшую опасность энтеробактеры представляют для новорожденных, так как вызывают:
- менингит;
- гнойное воспаление почек и мочевыводящих путей;
- некротический колит;
- тяжелые поражения кровеносной и лимфатической системы;
- гнойничковые и язвенные поражения кожи у грудничков.
Летальность при этом составляет от 55 до 80%.
Респираторные заболевания, вызванные Enterobacter cloacae, которые локализуются в горле, проявляются повышением температуры тела, слабостью и продуктивным кашлем.
Опасность данных инфекционных заболеваний заключается в том, что даже при грамотной своевременной терапии могут наблюдаться параличи, резкое падение кровяного давления, приводящее к потере сознания, асфиксия. Смертность составляет до 25%.
Энтеробактеры являются возбудителями бактеремий, при которых происходит интенсивное размножение микроорганизмов в крови, приводя к развитию патологий во всех внутренних органах.
У мужчин бактерии рода энтеробактер часто вызывают простатиты и уретриты. У женщин они становятся причиной воспалений органов мочеполовой системы, которые очень тяжело поддаются лечению.
Наиболее восприимчивыми являются люди, перенесшие серьезные травмы, больные сахарным диабетом, а также другими болезнями, подавляющими синтез клеток иммунитета.
Enterobacter cloacae: норма и патология
Многие бактерии относятся к условно-патогенной флоре. Они могут располагаться практически во всех отделах организма, чаще всего – в желудочно-кишечном тракте. Одним из представителей таких микроорганизмов является Enterobacter cloacae. Эти бактерии живут совместно с человеком постоянно, при этом ничем не вредят его состоянию.
Под действием неблагоприятных факторов они начинают усиленно размножаться, в результате чего становятся патогенными. Энтеробактерии распространены повсеместно, они могут обитать как в свободном состоянии (в реках, сточных водах, на поверхности растений), так и внутри организма человека и животных.
Enterobacter cloacae относятся к сапрофитам, живущим на слизистой оболочке тонкого и толстого кишечника, в дистальных отделах пищеварительного тракта.
Патогенные энтеробактерии: условное исследования на другие бактерии у грудничка, их характеристика и анализ кала для этого
В желудочно-кишечном тракте обитает множество условно-патогенных бактерий. При крепком иммунитете они не вызывают никаких патологий у человека.
Но как только защитные силы организма ослабевают, эти микробы начинают проявлять свои болезнетворные свойства. Одной из таких бактерий является Enterobacter cloacae.
Описание
Бактерии Enterobacter cloacae (Энтеробактер клоаке) представляют собой микроорганизмы палочковидной формы. Они не способны образовывать споры.
Эти бактерии являются анаэробными, они могут жить при полном отсутствии кислорода. Энтеробактеры довольно устойчивы к воздействию дезрастворов и большинства антибиотиков. Они содержатся в большом количестве в окружающей среде и попадают в организм чаще всего с пищей.
Ингалятор компрессорный: обзор лучших моделей, рейтинг, характеристики, инструкция, отзывы о производителях
Эти бактерии являются частью нормальной микрофлоры ЖКТ. Если их количество не превышает допустимые показатели, то никаких патологий у человека не возникает. Однако при падении иммунитета происходит активное размножение энтеробактеров, что может спровоцировать различные заболевания.
Патогенность
При неблагоприятных условиях микроорганизмы Enterobacter cloacae могут вызывать воспалительные процессы в разных органах. Обычно это происходит при резком ослаблении организма или на фоне других заболеваний. Бактерии могут поражать не только ЖКТ, но и другие органы: легкие, почки, мочевой пузырь. Это приводит к появлению следующих патологий:
- дисбактериоза кишечника;
- острого пиелонефрита;
- цистита;
- аспирационной пневмонии.
Активно размножаясь, энтеробактеры вытесняют полезные микроорганизмы. В результате у человека нарушается микрофлора в органах ЖКТ. Это приводит к ухудшению самочувствия, дальнейшему снижению иммунитета и высокой подверженности инфекциям.
Анализ кала
Как выявить чрезмерное размножение Enterobacter cloacae? Это можно сделать с помощью анализов кала или мочи на бакпосев. Рассмотрим эти исследования более подробно.

Концентрацию Enterobacter cloacae в кале определяют во время проведения анализа на дисбактериоз кишечника. Это исследование назначают, если у пациента имеются следующие симптомы:
- длительное повышение температуры до +38 градусов;
- периодическая рвота;
- диарея;
- примесь крови и слизи в испражнениях.
На пробу берут небольшой кусочек биоматериала, желательно с примесью слизи или крови (если есть). Кал необходимо доставить в лабораторию в течение 1 часа.
Специалисты проводят посев фекалий на питательные среды. Через 5 дней бактерии в биоматериале начинают размножаться. После этого подсчитывается количество микроорганизмов в 1 г кала. Их концентрацию измеряют в КОЕ (колониеобразующих единицах).
Исследование мочи
Для определения содержания Enterobacter cloacae в моче назначают анализ урины на бакпосев. Это исследование показано в следующих случаях:
- при беременности;
- при обнаружении бактерий или грибков в общем анализе мочи;
- при сахарном диабете;
- при признаках воспаления в органах выделения;
- при хроническом цистите, уретрите и пиелонефрите.
За 7 дней до проведения пробы нужно исключить из рациона острые, соленые и жирные блюда, а также спиртные напитки. За 2 недели до сдачи анализа необходимо прекратить прием антибиотиков.
Перед сбором мочи нужно тщательно вымыть наружные половые органы, не используя при этом антибактериальное мыло. Урину собирают утром в аптечный контейнер и доставляют в лабораторию в течение 2 часов. Затем проводится посев мочи на питательные среды. После этого определяется количество бактерий в 1 мл урины.
Нормы и расшифровка результатов
Каковы нормы содержания энтеробактеров в анализе кала? Максимально допустимая концентрация Enterobacter cloacae — 10 в степени 4 (104) колониеобразующих единиц (КОЕ) на 1 г биоматериала.
Превышение этой нормы может быть признаком дисбактериоза. Однако врач всегда обращает внимание на содержание в анализе и других видов условно-патогенных кишечных бактерий:
- клебсиелл;
- протеев;
- гафний;
- провиденций;
- морганелл;
- цитробактеров;
- серраций.
Повышение концентрации вышеперечисленных микроорганизмов и энтеробактеров свидетельствует о дисбиозе.
Рассмотрим расшифровку анализа мочи на бакпосев:
- Если результаты исследования показавают концентрацию энтеробактеров до 103 микробных тел на 1 мл, то человек здоров. Такие данные анализа являются нормой.
- При показателях более 104 энтеробактеров на 1 мл врач может подозревать инфекцию органов выделения. В этом случае необходимо пройти дополнительную диагностику.
- Если в расшифровке анализа показатель энтеробактеров превышает 105 микробных тел на 1 мл, то врач диагностирует истинную бактериурию.
Энтеробактериоз кишечника
Повышение концентрации Enterobacter cloacae в кале у ребенка — нередкое явление. Усиленное размножение таких бактерий в 50 % случаев диагностируется у детей в возрасте до 6 месяцев. Если содержание условно-патогенных микроорганизмов превышает допустимую норму, то врачи ставят диагноз — энтеробактериоз кишечника.
В детском возрасте эта патология протекает в довольно тяжелой форме. Она сопровождается следующей симптоматикой:
- стойким повышением температуры;
- беспокойством и плачем;
- отказом от еды;
- диареей, сменяющейся запорами;
- тошнотой и рвотой;
- выделением зловонных испражнений с примесью крови и слизи.
Острые проявления заболевания могут продолжаться от 7 до 10 дней. У взрослых энтеробактериоз протекает с такими же симптомами, как и у детей, но в более легкой форме.
Бактериурия
Если у пациента в моче отмечается концентрация энтеробактеров выше 105 микробных тел, то такое отклонение называется бактериурией. Оно может указывать на воспалительные процессы в органах выделения. Если это состояние протекает без выраженных клинических проявлений, то врачи говорят о бессимптомной бактериурии.

Если же у человека имеются явные симптомы воспаления в почках или мочевом пузыре (болевой синдром, высокая температура, расстройства мочеиспускания), то отклонением от нормы считается показатель энтеробактеров выше 104 микробных тел.
При этом врачи обращают внимание и на данные общего анализа мочи. Повышение концентрации энтеробактеров и количества лейкоцитов чаще всего свидетельствуют о пиелонефрите.
Лечение
Что делать, если в анализе кала обнаружено повышенное количество Enterobacter cloacae? Лечение энтеробактериоза у взрослого или ребенка должно быть комплексным. Медикаментозная терапия обязательно сочетается с соблюдением диеты.
Необходимо исключить из рациона сладости, мед, дрожжи, жареную и соленую еду. Такая пища способствует размножению условно-патогенной микрофлоры. Нужно стараться употреблять как можно больше кисломолочных продуктов, в их состав входят полезные лактобактерии.
Если обнаружена Enterobacter cloacae у ребенка в возрасте до 12 месяцев, то родителям необходимо тщательно следить за гигиеной малыша. Дети нередко инфицируются повторно сами от себя.
Поэтому нужно несколько раз в день кипятить соску и игрушки-грызунки. Ребенка необходимо тщательно подмывать после каждой дефекации. Это поможет предотвратить самозаражение и рецидивы энтеробактериоза.
Что касается питания, то самой лучшей едой для грудничка с энтеробактериозом является материнское молоко. С разрешения педиатра допускается прикорм в виде соков.
При энтеробактериозе назначают следующие группы лекарств:
- Пробиотики: «Линекс», «Бифидумбактерин», «Бифиформ». Они содержат живые штаммы полезных бактерий.
- Пребиотики: «Хилак Форте». В состав этих препаратов входят вещества, способствующе размножению полезных микроорганизмов.
- Синбиотики: «Гастрофарм», «Нормофлорин-Л». Эти средства содержат полезные бактерии и питательные вещества для их роста.
При выраженных диспепсических явлениях (рвоте, диарее) показан прием энтеросорбентов: «Смекты», «Энтеросгеля», «Полифепана», «Фильтрума».
Антибиотики назначают только при тяжелых формах энтеробактериоза. Условно-патогенные микроорганизмы довольно устойчивы к воздействию антибактериальных лекарств. Поэтому перед лечением необходимо провести тест на чувствительность микрофлоры к антибиотиков. Это поможет правильно подобрать препарат.
Если у пациента выявлены энтеробактеры в моче, то лечение будет зависеть от клинических проявлений. Бессимптомная бактериурия далеко не всегда требует медикаментозной терапии. Необходимость назначения лекарств может определить только врач.
Если же у пациента имеются симптомы пиелонефрита, уретрита или цистита, то необходимо сделать тест на чувствительность бактерий к антибиотикам, а затем пройти курс антибактериальной терапии.
Энтеробактерии
Энтеробактерии (лат. enterobacteriaceae) — семейство грамотрицательных (как и другие протеобактерии) палочкообразные (бациллы), споронеобразующие бактерии, длиной 1-5 мкм, со жгутиками для передвижения.
Эти бактерии — факультативные анаэробы, расщепляют углеводы с образованием муравьиной кислоты и других конечных продуктов формиатного брожения. Некоторые из них могут разлагать лактозу.
Множество представителей семейства являются частью микрофлоры кишечника человека и животных. Они представляют большое число нормальной микрофлоры человеческого организма и значительное количество патогенных микробов: сальмонелла, кишечная палочка, чумная палочка и др.